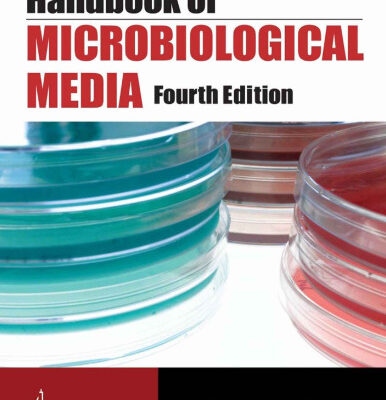

خرید و دانلود نسخه کامل کتاب Manual of Clinical Microbiology (2 Volume set) 80,500 تومان قیمت اصلی 80,500 تومان بود.43,000 تومانقیمت فعلی 43,000 تومان است.
خرید و دانلود نسخه کامل کتاب Handbook of Microbiological Media, Fourth Edition 68,500 تومان قیمت اصلی 68,500 تومان بود.31,000 تومانقیمت فعلی 31,000 تومان است.
فقط اینقدر👇 دیگه زمان داری با تخفیف بخریش
00روز
03ساعت
43دقیقه
01ثانیه
خرید و دانلود نسخه کامل کتاب Plant Cell Culture Protocols
83,500 تومان قیمت اصلی 83,500 تومان بود.46,000 تومانقیمت فعلی 46,000 تومان است.
تعداد فروش: 47
عنوان فارسی | پروتکل های کشت سلول های گیاهی |
---|---|
عنوان اصلی | Plant Cell Culture Protocols |
ویرایش | 1 |
ناشر | Humana Press |
نویسنده | Robert D. Hall (auth.), Robert D. Hall (eds.) |
ISBN | 9780896035492, 0896035492 |
سال نشر | 1999 |
زبان | English |
تعداد صفحات | 437 |
دسته | میکروب شناسی |
فرمت کتاب | pdf – قابل تبدیل به سایر فرمت ها |
حجم فایل | 25 مگابایت |
1 آیتم فروخته شده در 55 دقیقه
4 نفر در حال مشاهده این محصول هستند!
Categories: زیست شناسی, میکروب شناسی
توضیحات
آنتونی رابینز میگه : من در 40 سالگی به جایی رسیدم که برای رسیدن بهش 82 سال زمان لازمه و این رو مدیون کتاب خواندن زیاد هستم.
توضیحاتی در مورد کتاب
CPRO-DLO، واگنینگن، هلند. مجموعه ای جامع از تکنیک های مورد استفاده و کاربردی برای کشت سلول و بافت گیاهی. روش ها شروع کشت، نگهداری، دستکاری، کاربرد و ذخیره سازی طولانی مدت را پوشش می دهند. بر اصلاح ژنتیکی و تکثیر ریز تاکید دارد. برای محققین
اولین کسی باشید که دیدگاهی می نویسد “خرید و دانلود نسخه کامل کتاب Plant Cell Culture Protocols” لغو پاسخ
نقد و بررسیها
هنوز بررسیای ثبت نشده است.